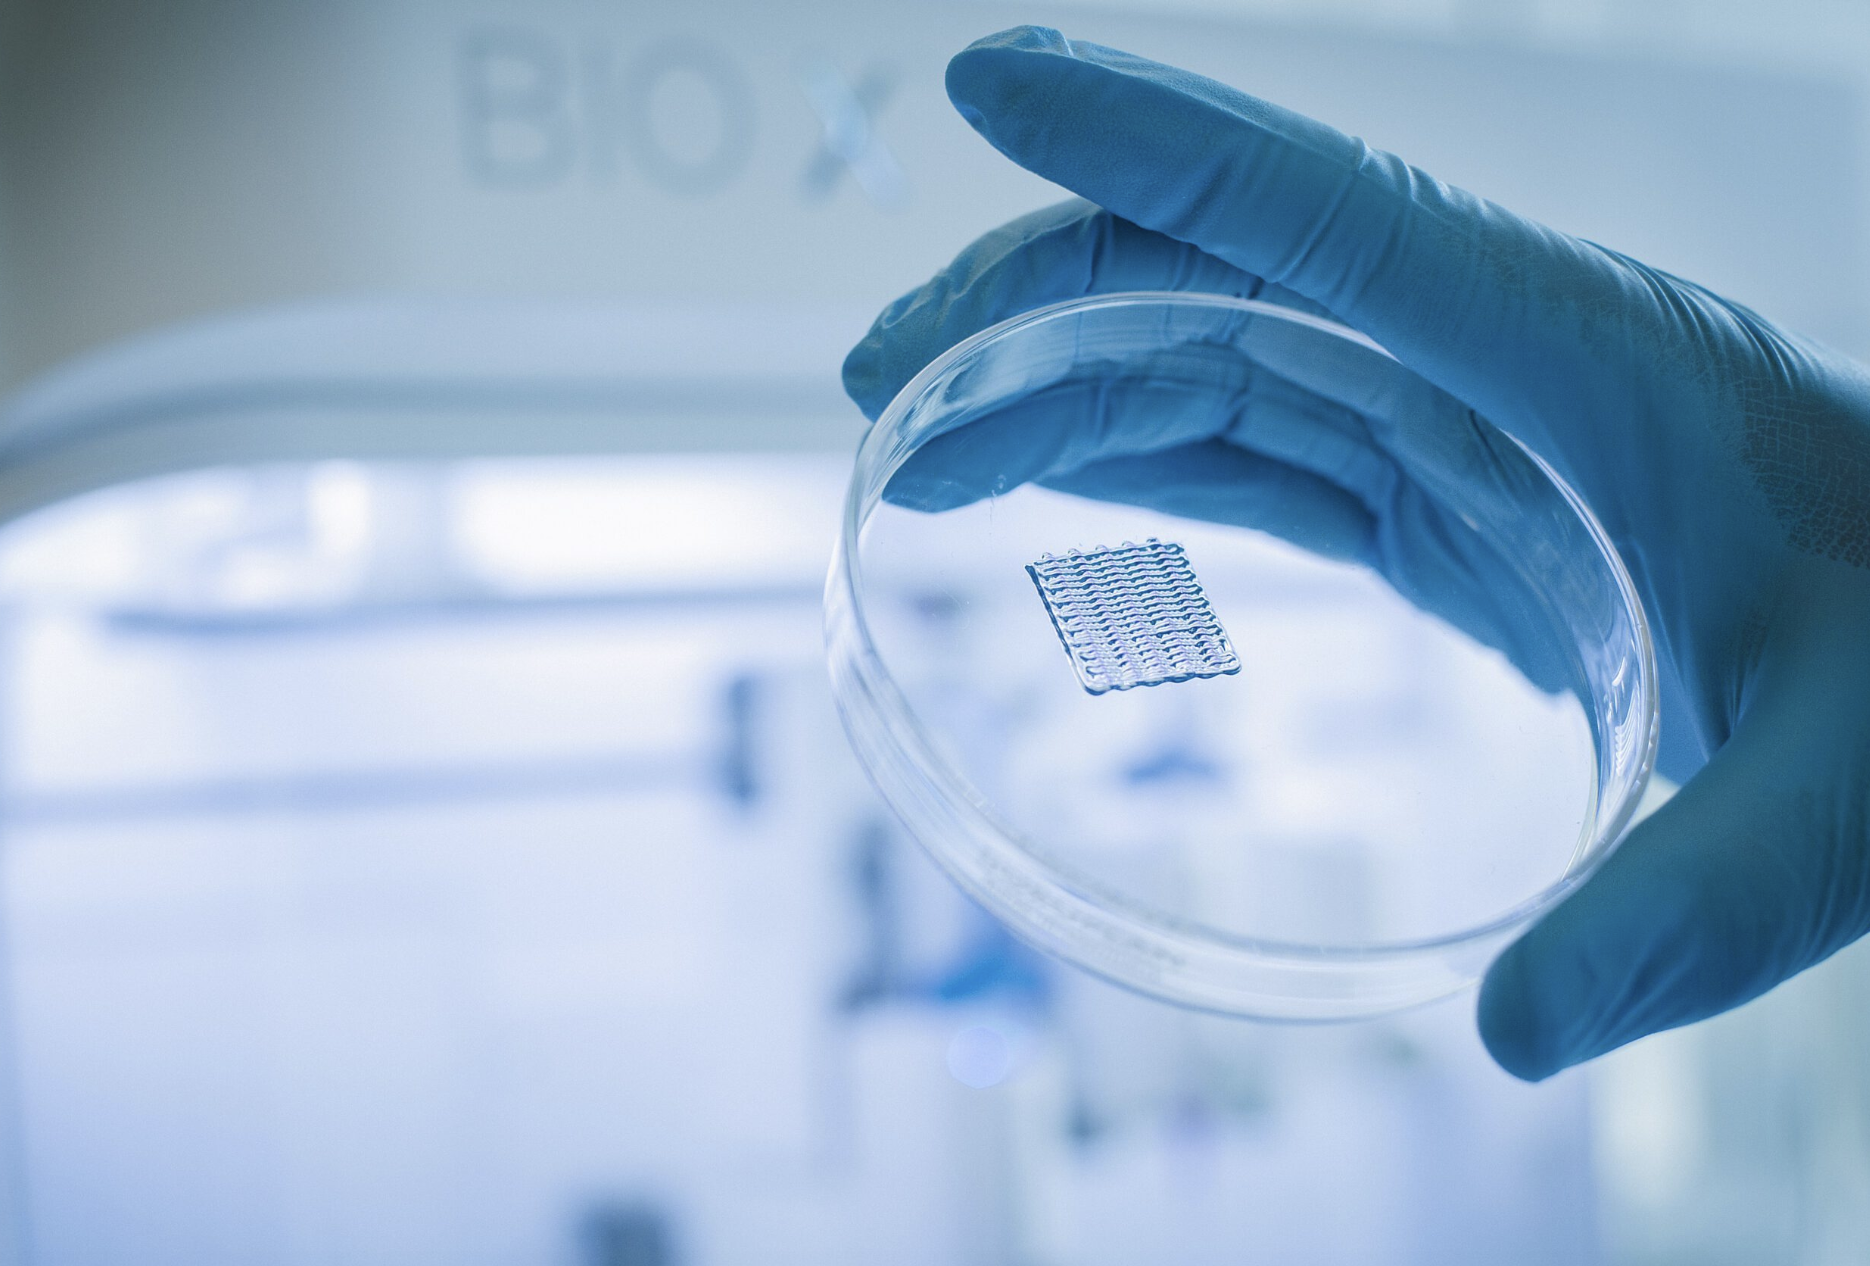
图像2026-3-17 09.47.png

5 年
手机商铺
公司新闻/正文
60 人阅读发布时间:2026-03-17 16:14
那些在皮肤科立下汗马功劳的小白鼠,它们用自己的身体为人类测试了无数药物,验证了成千上万种化妆品的安全性。但今天,想和大家聊聊一个正在改变这一切的神奇技术——3D打印皮肤。
它就像科幻电影里走出来的一样:一台打印机,几个装有细胞的“墨盒”,按下启动键,一层层“皮肤”就被打印出来。这听起来可能像天方夜谭,但在2026年的今天,这已经成为现实。

为什么要给小白鼠找“接班人”?
让我们先回到一个根本问题:为什么要用动物做实验?
当皮肤科医生给你开一支新药膏时,这支药膏背后是长达数年的研发历程。科学家需要知道:它会不会刺激皮肤?会不会引起过敏?能不能真正治疗疾病?在这些问题得到答案之前,必须有一个“替身”来承担风险。

长期以来,这个“替身”就是实验室里的小白鼠。它们为人类皮肤健康做出了巨大牺牲——被诱导产生类似人类湿疹、银屑病的症状,然后测试各种新药的疗效和安全性。
但随着科技发展和伦理意识的提升,人们开始寻找替代方案。3D打印皮肤技术应运而生,它可能是小白鼠理想的“接班人”。
这台“打印机”长什么样?
想象一下普通的办公室打印机,现在把里面的纸张换成一种特殊的“生物墨水”,把喷头换成能精确控制细胞位置的微细针头——你就大致明白了3D生物打印机的样子。
它不像我们常见的桌面3D打印机那样打印塑料或树脂,而是打印活的细胞。科学家们从人体皮肤中提取关键的细胞类型,将它们培养扩增,然后混合在一种特殊的凝胶状材料中,这就是所谓的“生物墨水”。

这个“生物墨水”可是有讲究的。它必须同时满足两个看似矛盾的要求:一方面,它要有足够的流动性,能从打印喷头中顺畅挤出;另一方面,它又要有足够的支撑力,让打印出来的“皮肤”保持形状,不会塌成一滩。目前常用的生物材料包括胶原蛋白、明胶、海藻酸钠等天然材料,它们与人体皮肤有着好的相容性。
一层一层“种”出皮肤
人体皮肤可不是简单的“一张皮”。从外到内,它分为表皮、真皮和皮下组织三层。表皮是最外面的保护层,真皮里有丰富的血管和神经,皮下组织则含有脂肪细胞,起到缓冲和保温作用。
3D打印皮肤的过程,就是一层一层地重建这个复杂结构:
科学家们会先在计算机中建立一个三维模型,就像建筑师画图纸一样,精确规划每一层的厚度、细胞密度和结构。然后,打印机开始工作:
第一层:打印真皮部分,里面混有大量的成纤维细胞,这些细胞能产生胶原蛋白,赋予皮肤弹性和强度。
第二层:在真皮上方打印表皮部分,这回用的是角质形成细胞,它们会逐渐分化、成熟,形成最外层的保护屏障。
整个过程中,打印机的定位精度可以达到微米级别,比头发丝还要细。这确保了细胞被精确地放置在它们应该在的位置。

2025年,梅奥诊所的研究团队取得了一项突破性进展:他们成功打印出完全“人源化”的皮肤模型,使用了植物来源的重组人胶原蛋白和人皮肤成纤维细胞、黑色素细胞及角质形成细胞。这种打印出来的皮肤在显微镜下与真实人体皮肤惊人地相似,甚至含有黑色素颗粒。
不仅仅是“皮肤”,更是“活的组织”
也许你会问:打印出来的这块东西,真的能叫“皮肤”吗?
答案是:它不仅是皮肤,还是活的皮肤。
打印完成后,这些细胞并没有“死掉”。在适宜的培养条件下,它们会继续生长、分化、相互作用。表皮细胞会逐渐形成多层结构,最外层的细胞会角化,形成与人体皮肤几乎一样的屏障。

梅奥诊所的研究显示,他们的3D打印皮肤表达involucrin和细胞角蛋白14,这两种蛋白是表皮分化的重要标志。虽然目前的模型中角质形成细胞的形态与天然皮肤略有差异——增殖层稍厚,角化层稍薄,但已经展现出明显的表皮分层结构,这是皮肤成熟的标志。
也就是说,这台打印机不是简单地堆砌细胞,而是在 “培育”一个有生命的组织。
更厉害的一步:给皮肤接上“血管”

传统皮肤组织工程面临的最大挑战是什么?营养供应。
在人体内,皮肤靠丰富的血管网络获取氧气和营养。而实验室培养的皮肤组织,一旦厚度超过几百微米,内部的细胞就会因为缺氧而死亡。这就像一座没有道路的城市,物资无法运送到深处。
2025年,一项来自意大利和美国的合作研究解决了这个难题。他们开发了一种巧妙的“牺牲打印”技术:先用一种特殊的“牺牲材料”打印出血管网络的通道,然后在周围打印真正的皮肤细胞,最后将牺牲材料洗掉,留下的就是空心的血管通道。
更神奇的是,他们还在通道内壁种上了血管内皮细胞,这些细胞会自然地生长、连接,最终形成功能性的血管网络。当连接上微型泵,让培养液在通道中流动时,整个皮肤组织就能获得持续的养分供应。
这还不是全部。中国科学院的研究人员在2026年初发表的研究中更进一步:他们利用同轴3D打印技术,一步法构建了预血管化的皮肤类器官模型。内层是温度响应性牺牲材料和内皮细胞形成的空心血管通道,外层是含有脂肪干细胞和皮肤成纤维细胞的仿生水凝胶基质。当这种预血管化的皮肤被移植到动物身上时,它能在大的皮肤缺损处形成丰富的新血管,加速伤口愈合,改善胶原蛋白重塑。
这项技术一旦成熟,将带来三大革命性的改变:
终结动物实验

欧盟早在2004年就禁止了化妆品动物实验,但禁令实施后,如何确保化妆品安全成了新问题。3D打印皮肤提供了完美的解决方案。
奥地利格拉茨工业大学和印度韦洛尔理工大学的研究团队开发的新型3D打印皮肤模型,能够评估新化妆品成分的吸收和安全性,特别适用于纳米颗粒等新材料的测试。这种皮肤模型可以维持人类皮肤细胞存活三周以上,真实模拟人体皮肤的结构和功能。
这意味着,未来你用的每一款面霜、每一支精华,都可以在实验室打印的皮肤上进行测试,既准确又人道。
精准的药物筛选

对于皮肤病患者来说,找到有效的药物往往是一个漫长的试错过程。3D打印皮肤可以改变这一现状。
利用患者的自身细胞,科学家可以打印出带有特定疾病特征的皮肤模型——比如银屑病、特应性皮炎或皮肤癌。然后在这些“疾病皮肤”上测试不同药物,观察哪种有效。
这种个性化医疗的愿景是:在未来,你的皮肤问题将首先在你的“替身皮肤”上得到解决,然后再应用到你自己身上。
烧伤患者的福音
对于严重烧伤或大面积皮肤损伤的患者,目前的标准治疗是自体皮肤移植——从患者身体其他部位取下一块健康皮肤,移植到伤口处。但这会产生新的伤口,而且如果烧伤面积过大,健康的供皮区可能不够用。
3D打印皮肤提供了另一种可能:从患者身上取一小块皮肤,在实验室扩增细胞,然后用3D打印机“打印”出一块足够大的新皮肤,移植回患者身上。这不仅避免了免疫排斥问题,还能实现精准匹配伤口形状和大小。
挑战与未来
当然,3D打印皮肤技术目前还面临一些挑战。
首先是结构和功能的完全复刻。人类皮肤中包含着毛囊、汗腺、皮脂腺、神经末梢等多种附属结构,目前的3D打印技术还无法实现单细胞分辨率下的精确组装,因此这些附属结构还难以打印出来。
其次是血管网络的充分构建。虽然科学家已经实现了初步的血管化,但要构建出能够与人体自身血管系统完美对接的网络,还需要更多研究。
第三是规模化生产。从实验室研究到临床应用,需要解决成本、标准化、法规审批等一系列问题。
但可以肯定的是,小白鼠的“接班人”已经站上了历史舞台。正如梅奥诊所的研究团队所说,3D打印皮肤技术“在个性化人类皮肤模型的高通量生产、减少动物实验以及再生医学应用方面展现出显著优势”。
南非比勒陀利亚大学的研究人员开发的“无细胞真皮支架”也已在动物实验中显示出加速愈合的效果,为未来3D生物打印天然皮肤铺平了道路。
下次当你走进皮肤科诊室,或者拿起一支新的护肤品时,不妨想一想:那层薄薄的、打印出来的皮肤组织,正在悄悄改变医学和美容的未来。而实验室里的小白鼠,或许终于可以“光荣退休”了。
从鼠到人,从牺牲到技术,这是科学进步的缩影,也是人类对生命尊重的体现。
你如何看待3D打印皮肤技术?你愿意尝试用这种技术打印的皮肤替代品吗?欢迎在评论区分享你的想法。